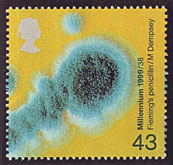

切手が語る医学(№89)
【 イ ギ リ ス( 英 国 )の 医 学 切 手(2)】
熊毛地区医師会 (田上病院) 古庄 弘典 |
世界各国から発行される切手には国名が必ず記載されています。例外はイギリスの切手で国名を入れなくてもよい唯一の国です。女王のマークが入っています。世界最初の切手発行がイギリスです。
 |
 |
||||
| ジェンナーの種痘 |
看 護 |
||||
| イギリス(1999)千年紀シリーズ(4種) |
|||||
|
 |
||||
| フレミングのペニシリン |
試験管ベビー |
||||
| イギリス(1999)千年紀シリーズ(4種) |
|||||
 |
 |
 |
|||
| イギリス赤十字125年 |
国連50年-自由 |
国連50年-平和 |
|||
| イギリス(1995)ヨーロッパ切手 |
|||||
このサイトの文章、画像などを許可なく保存、転載する事を禁止します。
(C)Kagoshima City Medical Association 2009